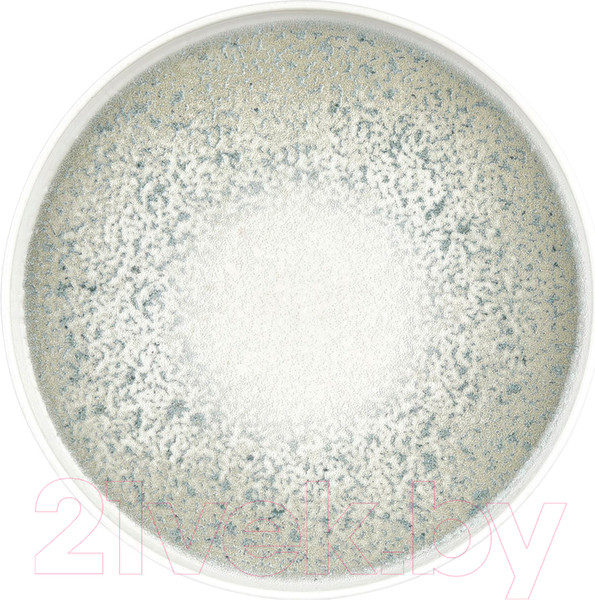
Изображение товара Тарелка столовая обеденная By Bone NM-HL-27-RD

Тарелка столовая обеденная By Bone NM-HL-27-RD

Материал
фарфор
Длина/диаметр
27 см
Ширина
27 см

Размеры
- Длина/диаметр
- 27 см
- Ширина
- 27 см
Страна производства: Турция
Производитель: Сима Порселен Ве Мутфак Эсялари Инс. Таах. Сан. Ве Тик. ЛТД. Сти., Гази Мустафа Кемаль Мах, Гелисим Сок. №2 Каракую-Торбали, Измир, Турция / Sima Porselen Ve Mutfak Esyalari Ins. Taah. San. Ve Tic. Ltd. Sti., Gazi Mustafa Kemal Mah, Gelisim Sok. №2 Karakuyu-Torbali, Izmir, Turkey
Импортер в РБ: ЗАО "ТВК", г.Минск, ул.Ванеева, д.48, 3 этаж, к.7
Производители оставляют за собой право изменять внешний вид, характеристики и комплектацию товара, предварительно не уведомляя продавцов и потребителей. Просим вас отнестись с пониманием к данному факту и заранее приносим извинения за возможные неточности в описании и фотографиях товара. Будем благодарны вам за — это поможет сделать наш каталог еще точнее!